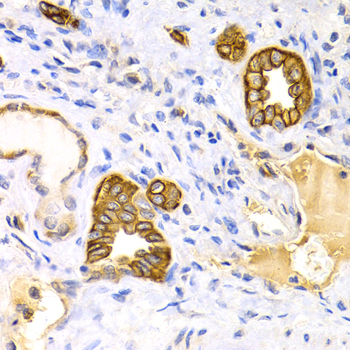
A2660: image 2

For quotations, please use our online quotation form, and you may also contact us by
service@kendallscientific.com
+1-888.733.6849 (Toll-free)
+1-617.299.7367 (Int’l))
+1-888.733.6849
Our customer service representatives are available 24 hours, Monday through Friday to assist you.| Reactivity | Human Mouse Rat |
| Tested applications | WB IHC |
| Recommended Dilution | WB 1:500 - 1:2000 IHC 1:50 - 1:200 |
| Calculated MW | 49kDa |
| Observed MW | Refer to Figures |
| Immunogen | Recombinant protein of human KRT15 |
| Storage Buffer | Store at -20℃. Avoid freeze / thaw cycles. Buffer: PBS with 0.02% sodium azide, 50% glycerol, pH7.3. |
| Synonym | K15; CK15; K1CO; |

Western blot analysis of extracts of various cell lines, using KRT15 antibody.
Immunohistochemistry of paraffin-embedded kidney cancer using KRT15 antibody at dilution of 1:200 (400x lens).

Immunohistochemistry of paraffin-embedded human stomach cancer using KRT15 antibody at dilution of 1:200 (400x lens).
The protein encoded by this gene is a member of the keratin gene family. The keratins are intermediate filament proteins responsible for the structural integrity of epithelial cells and are subdivided into cytokeratins and hair keratins. Most of the type I cytokeratins consist of acidic proteins which are arranged in pairs of heterotypic keratin chains and are clustered in a region on chromosome 17q21.2.this gene.
N/A